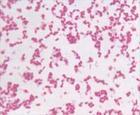
小兒先天性巨結腸

病因
 小兒先天性巨結腸
小兒先天性巨結腸小兒先天性巨結腸是由什麼原因引起的?
本病的病因目前尚不清,多數學者認為與遺傳有密切關係,本病的發病機理是遠端腸管神經節細胞缺如,或功能異常,使腸管處於痙攣狹窄狀態,腸管通而不暢,近端腸管代償性增大,壁增厚。本病有時可合併其他畸形。
現代醫學認為:
1.本病是一種起源於神經嵴的組織發育障礙所致的疾病。胚胎學的研究證實,從胚胎第5周起,來源於神經嵴的神經管原腸神經節細胞,沿迷走神經纖維由頭側向尾側遷移。整個移行過程,到胚胎第12周時完成。因此,無神經節細胞症是由於在胚胎第12周前發育停頓所致,停頓愈早,無神經節細胞腸段就愈長。尾端的直腸和乙狀結腸是最後被神經母細胞進化的,故是最常見的病變部位。由於腸壁肌層及黏膜下神經叢的神經節細胞完全缺如或減少,使病變腸段失去蠕動,經常處於痙攣狀態,形成一種功能性腸梗阻,天長日久,梗阻部位的上段結腸擴張,腸壁增厚,形成先天性巨結腸。至於導致發育停頓的原始病因,可能是在母親妊娠早期,由於病毒感染或其他環境因素(代謝紊亂、中毒等),而產生運動神經元發育障礙所致。 小兒先天性巨結腸
小兒先天性巨結腸2.認為與遺傳因素有關:自從50年代初Carter和Ward等對巨結腸的遺傳學比較系統的研究以來,後有許多學者陸續發表了這方面的研究成果。Zueher和Wilson報告,12個同胞有6例患者;Richordson和Brown描述了3個患巨結腸病者(父親)的7個兒子,有6人患巨結腸;Emanucl發現有1個家庭5個孩子都患巨結腸,且他們的母親與第2個丈夫婚後所生3個孩子又有1人受累,故支持遺傳因素。但對遺傳方式看法不一;Passarge認為,其符合簡單的孟德爾遺傳的證據較少,因而認為可能是一種異質性病原,並可能是性別修飾多基因遺傳,即遺傳閾值在性別間不同,和一般人比較,先天性巨結腸女性患者其後代患本病的危險性增加360倍;先天性巨結腸男性患者其後代患本病的危險性增加130倍。Emanucl和salmon等認為,巨結腸病遺傳因子可能在於第21對染色體異常。綜上所述,巨結腸是一種多基因遺傳性疾病,而且存在遺傳異質性。
3.環境因素:所謂環境因素,包括出生前(子宮內)、出生時和出生後起作用的全部非遺傳因素的影響。Touloukian等報告1例早產兒,因缺氧發生巨結腸症,他認為缺氧可導致毛細血管循環重新分配,血液離開腹部內臟去保護心、腦等與生命有關的器官,於是發生嚴重的“選擇性循環障礙”,改變早產兒未成熟遠端結腸神經節細胞的功能,繼而使之消失。Ehrenpries證實手術損傷可引起巨結腸。Lane和Toddl977年報告26例成人患巨結腸。還有人採用理化方法造成結腸暫時缺血,可成功地誘發實驗動物出現酷似人的巨結腸。因此,目前學者們已承認環境因素所致的獲得性巨結腸是存在的。
症狀
一、病史及體徵
90%以上患兒生後36~48小時內無胎便,以後即有頑固性便秘和腹脹,必須經過灌腸、服瀉藥或塞肛栓才能排便的病史。常有營養不良、貧血和食欲不振。腹部高度膨脹並可見寬在腸型,直腸指診感到直腸壺腹部空虛不能觸及糞便,超過痙攣段到擴張段內方觸及大便。
二、臨床表現:
 小兒先天性巨結腸
小兒先天性巨結腸2、營養不良發育遲緩長期腹脹便秘,可使患兒食慾下降,影響了營養的吸收。糞便淤積使結腸肥厚擴張,腹部可出現寬大腸型,有時可觸及充滿糞便的腸袢及糞石。直腸指檢:大量氣體及稀便隨手指撥出而排出。
3、巨結腸伴發小腸結腸炎是最常見和最嚴重的併發症,尤其是新生兒時期。其病因尚不明確,一般認為長期遠前幾天梗阻,近端結腸繼發肥厚擴張,腸壁循環不良是基本原因,在此基礎上一些患兒機體免疫功能異常或過敏性變態反應體質而產生了小腸結腸炎。也有人認為是細菌和病毒感染引起,但大便培養多無致病菌生長。結腸為主要受累部位,黏膜水腫、潰瘍、局限性壞死,炎症侵犯肌層後可表現漿膜充血水腫增厚腹腔內有滲出,形成滲出性腹膜炎。患兒全身發問突然惡化,腹脹嚴重、嘔吐有時腹瀉,由於腹瀉及擴大腸管內大量腸液積存,產生脫水酸中毒高燒、肪快、血壓下降,若不及時治療,可引起較高的死亡率。
檢查
1、活體組織檢查 取距肛門4cm以上直腸壁黏膜下層及肌層一小塊組織,病理證實無神經節細胞存在
 鋇劑
鋇劑3.活體組織檢查取距肛門4cm以上直腸壁黏膜下層及肌層一小塊組織,檢查神經節細胞的數量,巨結腸患兒缺乏節細胞。
4.肛門直腸測壓法測定直腸和肛門括約肌的反射性壓力變化,可診斷先天性巨結腸和鑑別其他原因引起的便秘。在正常小兒和功能性便秘,當直腸受膨脹性刺激後,內括約肌立即發生反射性放鬆,壓力下降,先天性巨結腸患兒內括約肌非但不放鬆,而且發生明顯的收縮,使壓力增高。此法在10天以內的新生兒有時可出現假陽性結果。
5.直腸黏膜組織化學檢查法 此乃根據痙攣段黏膜下及肌層神經節細胞缺如處增生、肥大的副交感神經節前纖維不斷釋放大量乙醯膽鹼和膽鹼酶,經化學方法可以測定出兩者數量和活性均較正常兒童出5~6倍,有助於對先天性巨結腸的診斷,並可用於新生兒。
發病機理
 小兒先天性巨結腸
小兒先天性巨結腸先天性巨結腸的基本病理變化是在腸壁肌間和黏膜下的神經叢內缺乏神經節細胞,無髓鞘性的副交感神經纖維數量增加且變粗,因此先天性巨結腸又稱為“無神經節細胞症”(aganglionosis),由於節細胞的缺如和減少,使病變腸段失去推進式正常蠕動,經常處於痙攣狀態,形成功能性腸梗阻,糞便通過困難,痙攣腸管的近端由於長期糞便淤積逐漸擴張、肥厚而形成巨結腸。實際上巨結腸的主要病變是在痙攣腸段,90%左右的病例無神經節細胞腸段位於直腸和乙狀結腸遠端,個別病例波及全結腸、末端迴腸或僅在直腸末端。新生兒期常因病變段腸管痙攣而出現全部結腸甚至小腸極度擴張,反覆出現完全性腸梗阻的症狀,年齡越大結腸肥厚擴張越明顯、越趨局限。
鑑別
 小兒先天性巨結腸
小兒先天性巨結腸小兒先天性巨結腸
新生兒:胎糞嵌頓綜合徵(無胎糞絞痛)和小左結腸綜合徵。這兩個是由鋇灌腸檢查明確,並可自限的短暫性梗阻。還要與其他原因引起的腸梗阻如低位小腸閉鎖、結腸閉鎖、胎便性便秘、新生兒腹膜炎等鑑別。
較大兒童:生理性梗阻,其以直腸壺腹內糞便及糞塊為特點。直腸測壓和指腸活檢可以是診斷性的。兒童應與直腸肛門狹窄、管腔內外腫瘤壓迫引起的繼發性巨結腸,結腸無力(如甲狀腺功能低下患兒引起的便秘)、習慣性便秘以及兒童特發性巨結腸(多在2歲以後突然發病,為內括約肌功能失調,以綜合懷保守治療為主)等相鑑別。
並發小腸結腸炎時與病毒、細菌性腸炎或敗血症腸麻痹鑑別。
治療
小兒先天性巨結腸應該如何治療?
治療原則
1.保守治療:適用於超短形先天性巨結腸病兒,新生兒。先用保守治療,待6個月後,再行根治手術;
2.結腸造婁:新生兒經保守治療失敗或患者病情嚴重或不具備根治術,均適用結腸造婁術;
3.根治手術:適用於所有巨結腸病兒。
(1)Swenson:切除整個受累部位並且將正常腸管吻合在近肛門水平。
 小兒先天性巨結腸
小兒先天性巨結腸(3)Duhamel;在肛門水平將未受累腸端背-背吻合到直腸。
痙攣腸段短、便秘症狀輕者,可先採用綜合性非手術療法,包括定時用等滲鹽水洗腸(灌洗出入量要求相等,忌用高滲、低滲鹽水或肥皂水),擴肛、甘油栓、緩瀉藥,並可用針炙或中藥治療,避免糞便在結腸內淤積。若以上方法治療無效,雖為短段巨結腸亦應手術治療。
凡痙攣腸段長,便秘嚴重者必須進行根治手術,目前採用最多的手術為①拖出型直腸乙狀結腸切除術(Swenson´s術);②結腸切除直腸後結腸拖出術(Duhamel´s手術);③直腸黏膜剝離結腸於直腸肌鞘仙拖出切除術(Soave´s手術)。如患兒發生急性小腸結腸炎、危像或營養發育障礙,不能耐受一次根治手術者,應行靜脈補液輸血,改善一般情況後再行根治手術,如腸炎不能控制、腹脹嘔吐不止,應及時作腸造瘺,以後再行根治術。
療效評價
1.治癒:症狀消失,排便正常或偶有污便。
2.好轉:症狀消失,排便基本正常,常有便失禁。
3.未愈:症狀仍在,或排便完全失禁。
預防
小兒先天性巨結腸應該如何預防?
先天性巨結腸的診斷和治療近年來有了很大進步,患兒若能得到早期診斷早期手術治療,術後近期遠期效果較滿意。但高,有些患兒術後大便次數多或失禁,則需較長時間進行排便訓練。
併發症
急性小腸結腸炎
急性小腸結腸炎1.慢性便秘
2..急性小腸結腸炎
3..腸穿孔
4..水、電解質代謝紊亂
5.繼發感染,休克甚至死亡
